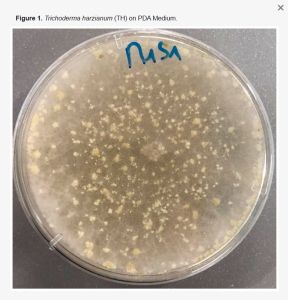

What this new paper is about
PRIMA-SAFE has a new open-access publication that addresses a very practical question for Mediterranean and water-scarce regions: when treated wastewater is reused for irrigation, how can we keep soils productive while reducing long-term concerns related to heavy metals and potential exposure risks? The study, published in Environments, explores an integrated “myco–phyto” concept that combines a beneficial soil fungus, Trichoderma harzianum, with faba bean (Vicia faba) cultivation under wastewater irrigation conditions, focusing on how this pairing influences soil metal behavior and overall safety assessment

The headline takeaways
The main message is that biological management at the soil–crop interface can be a meaningful part of safe reuse strategies. In the tested setup, introducing Trichoderma harzianum alongside faba bean cultivation improved soil outcomes by reducing the overall metal burden compared with comparable scenarios without fungal inoculation, reinforcing the idea that soil microbiology can act as a “buffer” in reuse contexts. A second, equally important point is that crop genetics matter: the paper compares different faba bean varieties and shows they do not behave identically in the soil–plant system, meaning variety selection can influence whether the system leans more toward soil decontamination performance or toward minimizing metal accumulation in plant tissues. This “systems view” fits PRIMA-SAFE’s goal of supporting reuse that is not only technically feasible, but demonstrably safe and context-appropriate.
Why this matters for PRIMA-SAFE
PRIMA-SAFE is about improving safety in agricultural water reuse by combining treatment options with monitoring and risk assessment, and this publication contributes a field-relevant mitigation lever that is low-cost in principle and compatible with agronomic practice. Rather than relying only on upgrading treatment trains, the work supports complementary approaches that manage risk where exposure actually happens: in the soil–plant interface. The study also frames outcomes using standard human-health risk assessment logic (including indicators used to evaluate carcinogenic and non-carcinogenic risk), which is essential because it translates measurements into the language used by regulators and stakeholders when judging whether a reuse scenario remains within an acceptable safety envelope.

